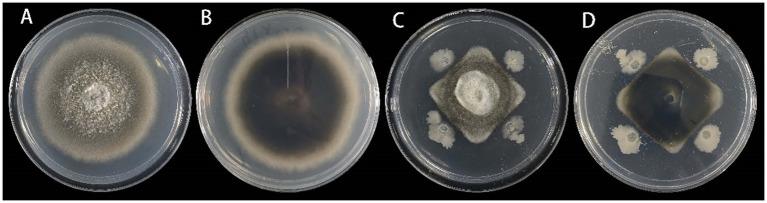
https://cdn.ncbi.nlm.nih.gov/pmc/blobs/c22d/11519681/6f2f5e3bb5d7/fmicb-15-1459868-g007.jpg

叶枯病初步研究及作为生物防治剂的筛选
Preliminary study on leaf blight and screening of as a biocontrol agent.
作者信息
Yang Xin, Dang You-Chao, Chen Jing-Zhong, Xu Ke-Cheng, Dai Dao-Die, Sun Qing-Wen
机构信息
College of Pharmacy, Guizhou University of Traditional Chinese Medicine, Guiyang, China.
Guizhou Key Laboratory for Raw Material of Traditional Chinese Medicine Guiyang, Guiyang, China.
出版信息
Front Microbiol. 2024 Oct 15;15:1459868. doi: 10.3389/fmicb.2024.1459868. eCollection 2024.
INTRODUCTION
This study aimed to identify the pathogen responsible for leaf blight in , investigate its biological characteristics, and identify effective synthetic fungicides. Additionally, this study examined changes in physiological and biochemical indices of leaves following pathogen infection and screened biocontrol bacteria that inhibit the pathogen growth, providing a scientific basis for preventing and managing leaf blight in .
METHODS
Pathogens were isolated from the interface of healthy and infected leaf tissues and identified through morphological and molecular biological methods. Amplification and sequencing of three genomic DNA regions-internal transcribed spacer region, translation elongation factor 1-α, and glyceraldehyde-3-phosphate dehydrogenase of ribosomal DNA-were performed, followed by the construction of a phylogenetic tree. The biological characteristics of pathogens under various temperature and pH conditions and different nitrogen and carbon sources were analyzed using the mycelial growth rate method. The antifungal effects of 13 chemical agents were evaluated using the poisoned medium method and mycelial growth rate method. Changes in physiological and biochemical indicators post-infection were also assessed. An antagonistic experiment was conducted to screen for biocontrol bacteria.
RESULTS
A total of 29 potential pathogenic strains were isolated from infected leaf tissues, with Koch's Postulates confirming as a key pathogen causing the disease. Growth analysis of revealed optimal growth at 20°C and pH 6, with lactose or maltose serving as the most suitable carbon source and histidine as the preferred nitrogen source. Among the 13 synthetic fungicides tested, strain DHY4 exhibited the greatest sensitivity to 400 g/L flusilazole. Significant differences ( < 0.05) were observed in superoxide dismutase, phenylalanine ammonia-lyase, peroxidase, polyphenol oxidase, catalase, and malondialdehyde levels between treated and control groups 3 days post-inoculation. The biocontrol strain DYHS2, identified as a strain of , demonstrated an inhibition rate of 51.80% against in dual-culture experiments and showed a relative inhibition rate of 78.82% in detached leaf assays.
DISCUSSION
These findings provide valuable insights into the newly identified causal agent of leaf blight in and its biological characteristics, underscoring the potential of DYHS2 and synthetic fungicides such as flusilazole as effective disease management strategies.
引言
本研究旨在鉴定引起[具体植物名称]叶枯病的病原菌,研究其生物学特性,并确定有效的合成杀菌剂。此外,本研究还检测了病原菌感染后叶片生理生化指标的变化,并筛选出抑制病原菌生长的生防细菌,为[具体植物名称]叶枯病的防治提供科学依据。
方法
从健康与染病叶片组织交界处分离病原菌,并通过形态学和分子生物学方法进行鉴定。对核糖体DNA的三个基因组DNA区域——内转录间隔区、翻译延伸因子1-α和甘油醛-3-磷酸脱氢酶进行扩增和测序,随后构建系统发育树。采用菌丝生长速率法分析病原菌在不同温度、pH条件以及不同氮源和碳源下的生物学特性。采用含药培养基法和菌丝生长速率法评估13种化学药剂的抑菌效果。还评估了感染后生理生化指标的变化。进行拮抗试验以筛选生防细菌。
结果
从染病叶片组织中总共分离出29株潜在病原菌,柯赫氏法则证实[具体病原菌名称]是导致该病的关键病原菌。[具体病原菌名称]的生长分析表明,其在20°C和pH 6条件下生长最佳,乳糖或麦芽糖是最适宜的碳源,组氨酸是首选氮源。在所测试的13种合成杀菌剂中,菌株DHY4对400 g/L氟硅唑表现出最大敏感性。接种3天后,处理组和对照组之间的超氧化物歧化酶、苯丙氨酸解氨酶、过氧化物酶、多酚氧化酶、过氧化氢酶和丙二醛水平存在显著差异(P < 0.05)。经鉴定为生防菌株DYHS2的[具体菌株名称],在双培养试验中对[具体病原菌名称]的抑制率为51.80%,在离体叶片试验中的相对抑制率为78.82%。
讨论
这些发现为新鉴定的[具体植物名称]叶枯病病原菌及其生物学特性提供了有价值的见解,强调了生防菌株DYHS2和氟硅唑等合成杀菌剂作为有效病害管理策略的潜力。